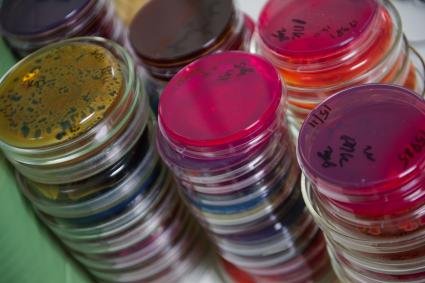

Пресс-тур, приуроченный к 25-летию образования Союзного государства Беларуси и России. Гомель. 1 день

Антон Челышев, Елена Беликова, Виктор Водолацкий и Олег Рой

Елена Беликова и Виктор Водолацкий

Виктор Водолацкий

Виктор Водолацкий

Олег Рой

Пресс-конференция о деятельности Центра "Воин" в редакции КП

Виктор Водолацкий

Антон Челышев, Елена Беликова, Виктор Водолацкий и Олег Рой